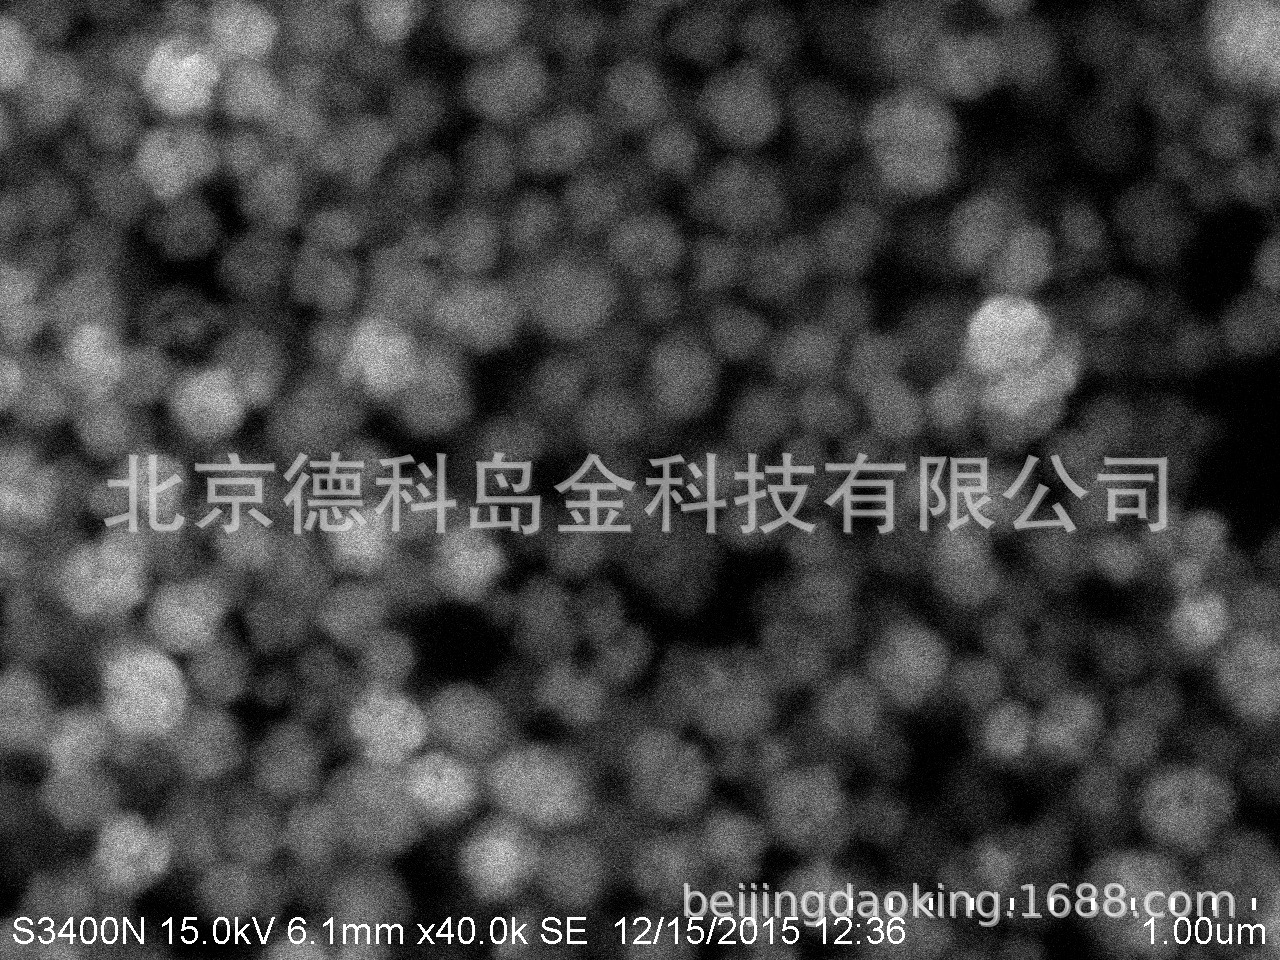
钛酸钡100

Поставка высококачественного высокочистого нано-титаната бария 30 нм 99,9% нано-титанат бария
Цена
¥150.00 / ≈ 1 936 ₽
MOQ: 1 pcs
1шт - ¥150.00
Продавец
北京德科岛金科技有限公司
Рейтинг
5
Продано
1
Всего
В наличии
197
SKU суммарно
Offer ID: 37883830706
Оформить заказ
Спецификация:
| Изображение | Спецификация | Цена (CNY / RUB) | В наличии | SKU ID | Кол-во / Корзина |
|---|---|---|---|---|---|
📦 | 100g | ¥200.0 / ≈ 2 581 ₽ | 99 | 5641920884075 | |
📦 | 50g | ¥150.0 / ≈ 1 936 ₽ | 98 | 5641920884076 |
Статистика продавца
4.5
Сервис
Источник: API 1688
5.0
Логистика
Источник: API 1688
5.0
Споры
Источник: API 1688
5.0
Оформление
Источник: API 1688
3.0
Консультация
Источник: API 1688
10%
Повторные покупки
Источник: API 1688
5.0
Постпродажное
Источник: API 1688
100%
Ответ ≤48ч (30д)
Источник: API 1688
Свойства товара
Происхождение Beijing
Модель DK-BaTiO3-100
Нужно ли импортировать No
Бренд DK nano
Содержание активного вещества 99
Номер товара DK-BaTiO3-001
Технические характеристики продукта 30nm 99.9%
Стандарты внедрения White
Основная цель Pyroelectric sensors; semiconductor ceramics; varistors; photoelectric devices; ceramic capacitors; dielectric amplifiers
CAS 12047-27-7
Рекомендуемые услуги Nano
Является ли это опасным химическим веществом? No
Название продукта Nano barium titanate
Описание товара
| 纳米钛酸钡 100nm 99.9% | |
|